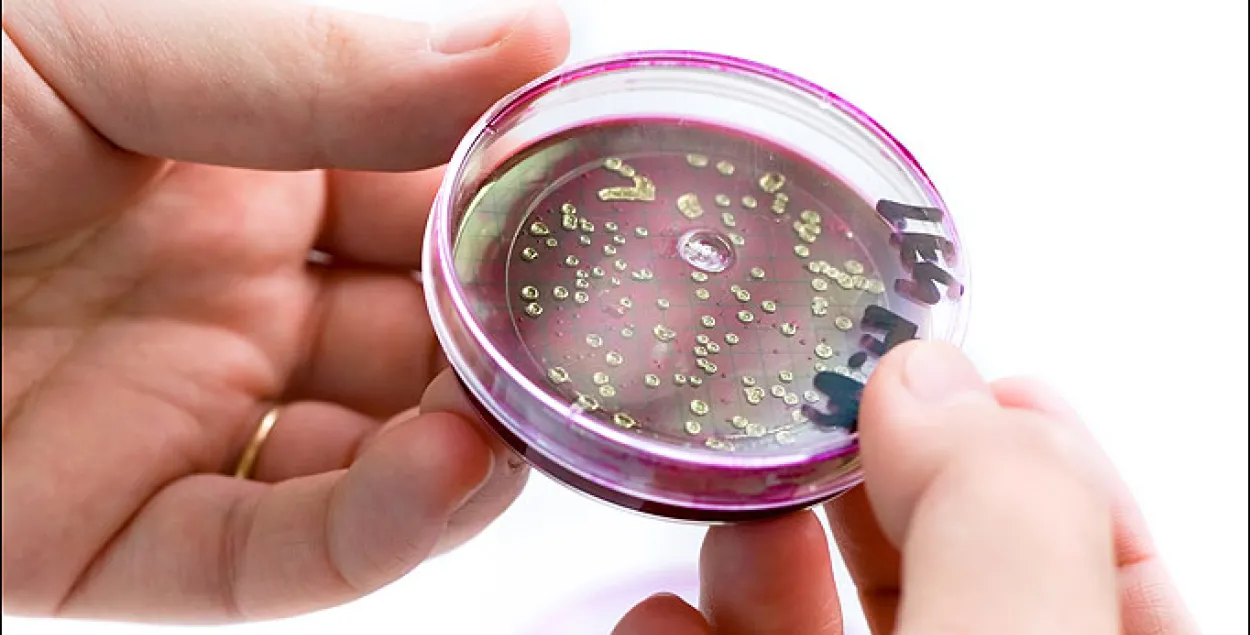

Рассельгаснагляд знайшоў кішэчную палачку ў беларускіх сасісках
Рассельгаснагляд выявіў кішэчную палачку ў пастэрызаваным малацэ і сасісках беларускай вытворчасці. Як паведамляе БелаПАН, супрацоўнікі ўпраўлення ведамства па Цвярской і Пскоўскай абласцях адабралі пробы пітного пастэрызаванага малака 3,2% тлустасці вытворчасці Мінска малочнага заводу №1. Тавар паступіў праз пункт перасячэння мяжы ў Себяжскім раёне Пскоўскай вобласці. 2,2 тоны груза суправаджаліся ветэрынарным сертыфікатам Мытнага саюза. Лабараторныя даследаванні пробаў малака паказалі, што ў ім ёсць бактэрыі групы кішэчнай палачкі.
Таксама не адпавядаюць нарматыўна-тэхнічнай дакументацыі сасіскі “Малочныя смачныя” вытворчасці Магілёўскага мясакамбіната. Груз агульнай вагой 3,6 тоны таксама ішоў праз Пскоўскую вобласць і меў сертыфікат Мытнага саюза. У сасісках знайшлі бактэрыі групы кішэчнай палачкі, а таксама выявілі перавышэнне колькасці мезафільных аэробных і факультатыўна-анаэробных мікраарганізмаў.
Спецыялісты Рассельгаснагляду адзначаюць, што высокае ўтрыманне гэтых мікраарганізмаў у прадуктах харчавання можа прывесці да харчовых атручэнняў, энтэрытаў, энтэракалітаў у спалучэнні з сіндромам агульнай інтаксікацыі, якія ўяўляюць небяспеку для здароўя чалавека.